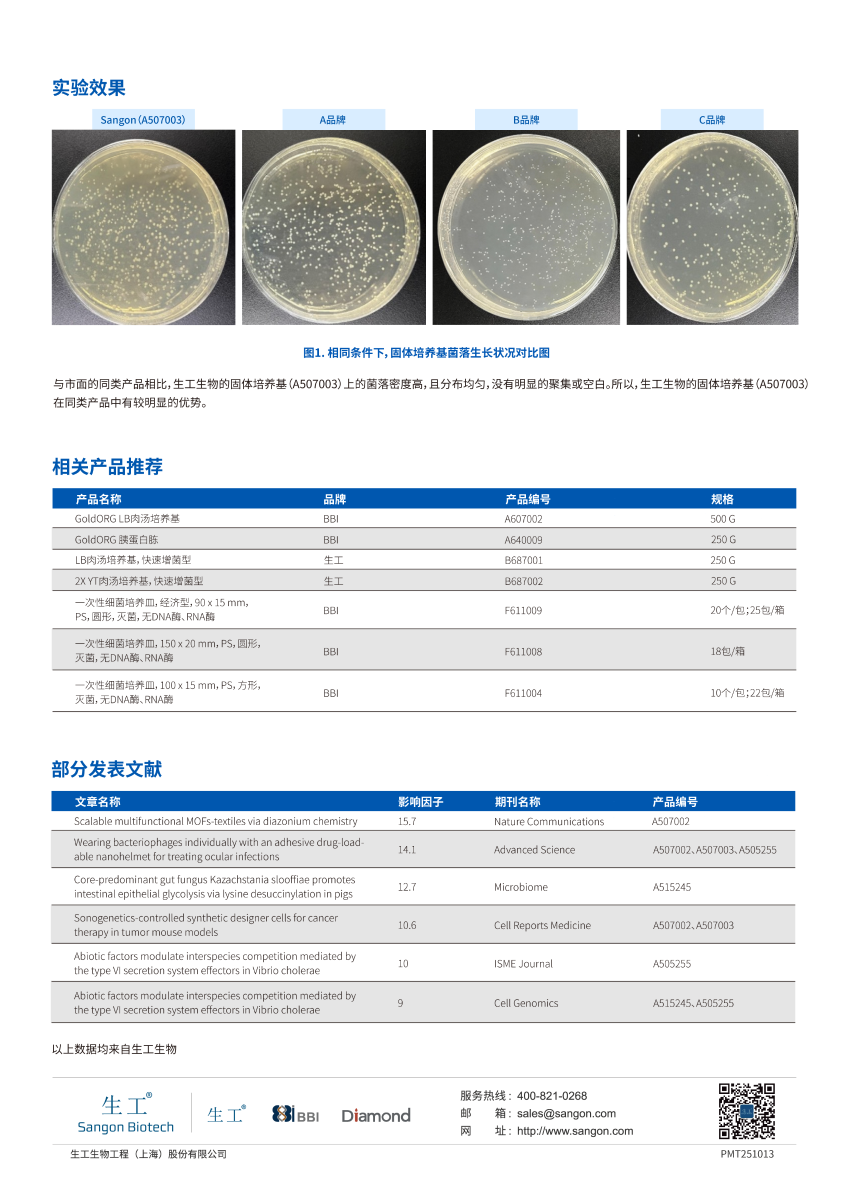

产品分类
在线客服的工作时间为周一至周五 9:00~17:00
非工作时间无法及时给您回复,请选择“点击留言”,我们将在工作日第一时间回复您
账户、订单咨询
账户注册
订单咨询
配送与催促
意见反馈
引物合成与设计
常规引物
修饰引物
引物设计
常规产品
试剂、试剂盒
蛋白类产品
细胞类产品
耗材、仪器
抗体,多肽产品
一抗、二抗
抗体磁珠
标签/内参抗体
多肽合成
一代测序服务
基本测序
克隆测序
STR分型
T-RFLP分型
高通量测序服务
转录调控测序
微生物分类测序
基因组测序
靶区域捕获测序
基因分析服务
基因检测
基因获取
RNA干扰
基因组改造
基因合成服务
基因合成、调取
质粒构建、改造
质粒提取
密码子优化
蛋白技术服务
蛋白表达与纯化
蛋白组学
代谢组学
蛋白理化分析
细胞与抗体服务
抗体制备
免疫学检测
细胞服务